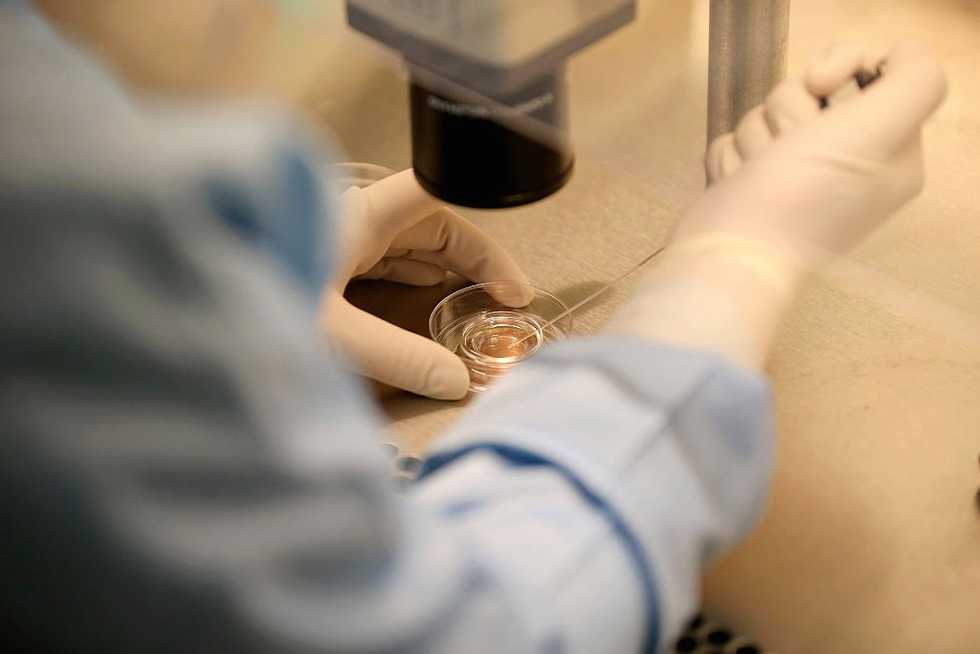

(Photo by Christopher Furlong/Getty Images)

By Jonathan Boldt
Infertility is one of the most gut-wrenching and emotionally draining experiences known to man (and woman) kind — and finding ways to deal while learning to still live a satisfying existence can be a difficult task.
Many different things can cause infertility, but no matter the cause, it leaves everyone asking the same question: What did I do wrong?
The Ideal
There is an unspoken order to life and certain events are supposed to unfold in a fairly consistent manner. After elementary school and junior high, we all move on to our high school years with an eye toward the future and begin to plot out what is important and what is expected.
The all-American youngster begins to envision a life trajectory that looks something like this:
Life can go off course at any point along the way, but one of the hardest trials to deal with is checking off each and every one of those items on your list, one at a time, and then just waiting and waiting for that last one.
Whether it's an awkward exchange with old ladies at church or a Sunday dinner at grandma's house, trying to explain why you haven't had children yet gets old pretty quick.
The Reality
After eight years of trying to conceive, my wife and I are resigned to the fact that it will likely take extraordinary (and expensive) measures to have a child of our own naturally. Adoption has always been an option but has yet to feel like the right thing to do (and trust me, there is no shortage of people asking us if we have thought about it).
One of the biggest stumbling blocks between couples can be finding ways to communicate feelings and expectations. Whether it’s justified or not, men are stereotyped as being poor communicators — and sometimes it really is for good reason.
Here's how a guy can cope:
Say it Out Loud.
We may not say it out loud (and probably won’t); we may not seek help emotionally (honestly, the odds of that happening are slim to none); and we, for sure, never want to admit that we just might be "shooting blanks." But we feel it all. If you are honest and open, communication not only becomes easier but more fun as well.
One day at a doctor's appointment for my wife, I got to talking with a friend of mine, who is a physician's assistant, about his own struggles with infertility. It was the first time I had a conversation with anyone other than my wife about some of the funny things we have encountered over the years. It might sound cliché but sometimes laughter truly is the best medicine.
Learn to Laugh.
Guys, it's tough to admit you are wrong or don't have all the answers, but once you let down your guard and show your wife you are hurting too, a bond is formed and finding ways to laugh becomes exponentially easier.
Figuring out how to laugh (at myself most of the time) and having a sense of humor has been the key to maintaining strength in my marriage. Guys tend to keep to themselves when it comes to topics like this, but the power and importance of opening up and communicating with your loved ones cannot be overstated.
Learn to Enjoy Her Texts and Phone Calls All Day.
Most married men know exactly what I'm talking about. Our wives love to instant message, text, Facebook and call pretty much every hour on the hour. If there is tension at home, this ends up wearing on you. But if you are able to find ways to look forward to her communications, she will notice — and the sincerity actually means a lot to her.
Re-Examine your Expectations.
While re-examining your expectations can be depressing, with patience and love, unity is possible. If a natural-born child is out of the question, adoption is a more than viable way of creating a family.
Serve Others.
It might sound cheesy, but serving others can help to fill the void. When you think about it, parenthood is the ultimate outlet for service, so the natural way to feed that need is to turn outward and focus on serving the people you are closest to.
The hopes and dreams of newlywed couples vary, the timing of life events do as well. When those hopes and dreams begin to slip away it takes a lot of work to stay strong.
Of course having children (even just one child) would be like winning the lottery, but as long as your spouse is your best friend and you can laugh together no matter what — you've won the jackpot.
Finding ways to connect with others facing the same challenges can be very helpful and important. A few years ago I got to know a physician's assistant at the doctor’s office I went to and he had experienced a lot of the same things I had. I had been contemplating writing a book highlighting the ridiculous things people say to you while trying to conceive and the crazy stories that come from those interactions.
My wife and I got together with Steve and Kristina Ruiz and recorded everything that made us laugh and even cry and then I went to work putting the book together, ‘Shooting Blanks: A Husband’s Perspective on Missing the Mark and Dealing With Infertility.’ It hasn’t hit the New York Times best-seller list just yet but it has led to some amazing opportunities.
Steve and I have done local TV and radio shows in the Salt Lake City area as well as with HuffPost live. That was surreal, being part of a panel with the head of men’s fertility at Cornell. We have also had the privilege of being guests with The Making Dads Summit for the past two years. This year’s summit will be June 13th -17th and will have an amazing line-up of speakers. If you are interested in signing up, just go to their website and register.
Jonathan Boldt is a daily contributor for GlennBeck.com. He studied journalism at Utah Valley University and interned at the Deseret News in Salt Lake City. He has since worked as the sports editor for papers in Oregon and New Mexico.
–
TheBlaze contributor channel supports an open discourse on a range of views. The opinions expressed in this channel are solely those of each individual author.